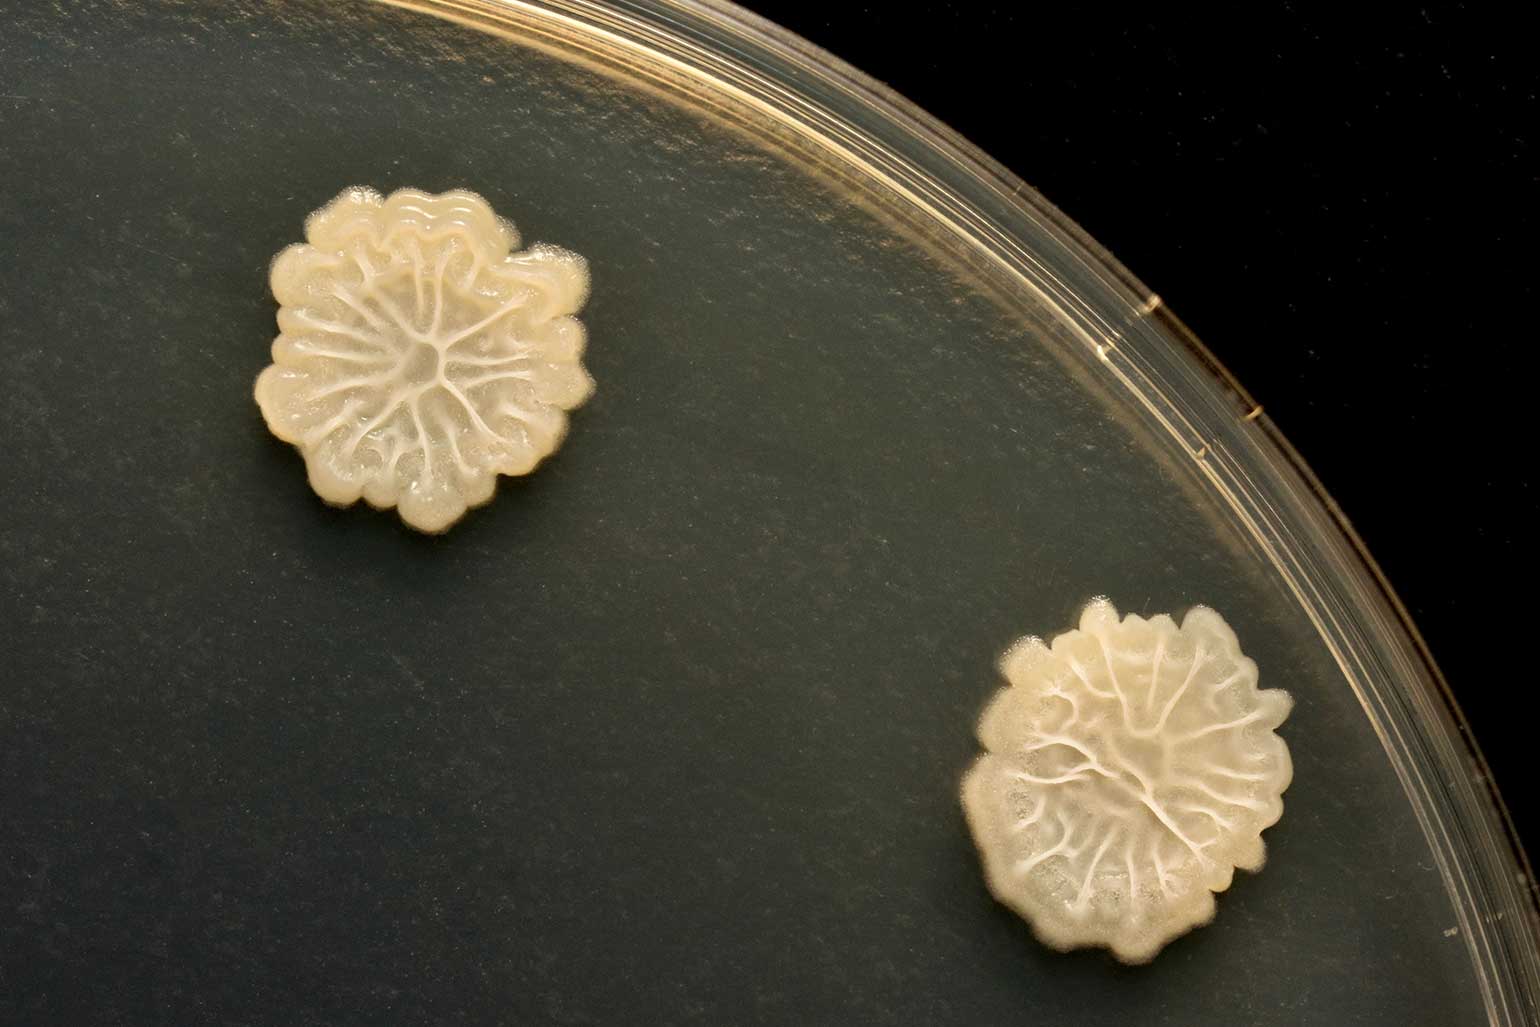
natto-2_003

今回は、納豆を作る際に欠かせない納豆菌についてお話させて頂こうかと思います。納豆菌は、枯草菌(こそうきん)と呼ばれる細菌の一種です。ご存じの通り、納豆は日本で生み出された大豆を発酵させることによって作られる食品です。味噌を始めとする大豆を発酵させた食品類は少なくとも8世紀頃には日本に伝わっていたようです。納豆が生み出されたのがいつなのかは諸説あるようですが、納豆が一般的にも食されるようになったのは江戸時代以降のこと。納豆が納豆菌による発酵作用によって作られることが発見されたのは、本格的に研究が進められた明治時代終わり頃~大正時代のことです。それらの研究によって、衛生的かつ、安定した納豆菌の培養方法や納豆の製造方法が確立され、昭和時代(もっと詳しく言えば、第二次世界大戦後)になってようやっと納豆は日本の日常食として広まりました。主に関東地方以北の地域の食文化として広まったんです。東日本地域に比べて、西日本地域において納豆を常食することが少ないのはそのせいだとか。現在は各メーカーが商品毎に異なった納豆菌を用いた納豆を作っています。近年ですと、匂いが軽減されたものや、栄養強化がなされた納豆が作られるように改良された新しい納豆菌なんかも生み出されていますね。ちなみに、それらの原株となっている納豆菌は”宮城野株”、”高橋株”、”成瀬株”と言う3種類なんだそうです。

納豆菌は非常に繁殖力や抗菌作用が強いことで知られています。生存できる環境範囲が非常に広いんです。氷点下の環境にも耐えられる一方で、100℃の熱水にさらしても死滅しない。胃酸への耐久度も高く、乾燥状態や真空状態、紫外線にも耐久性を有する等々。また、他の細菌類からの攻撃に対する耐久力も強いんです。これは、納豆菌が”芽胞”と呼ばれる外殻を有することによって、外部環境の影響を受けにくいためなんだそうです。ただ一方で、納豆菌の有する繁殖力や抗菌作用の強さは、他の発酵食品の製造にとっては非常に弊害になるものでして。その強い増殖作用によって、他の菌類や微生物の活動を排除してしまうんだそうです。かつては腹痛や下痢症状に処方される整腸薬のようなものとしても利用されていたくらいですから、まぁ納得いきますよね? 故に、麹菌や酵母菌、乳酸菌等を用いた発酵食品を取り扱う環境においては持ち込み厳禁のものとされています。日本酒を製造する酒蔵や味噌/醤油蔵、チーズやヨーグルト等の乳製品、パン類の製造所等に立ち入る方々は”納豆を食さない”、なんてこともあるんだとか。なかなか面白い話ですよね?
そんな納豆菌ですが、現在でもその研究は広く進められています。健康食品や薬剤開発の分野は勿論のこと。食用以外の分野での利用なんかも期待されているんですね? 農業分野では、作物類の病気を予防する生物農薬や土壌改善への利用研究なんかはよく知られているでしょうか。納豆菌。まだまだ、色んな効果が期待できそうです(≧▽≦)
_op.png)








